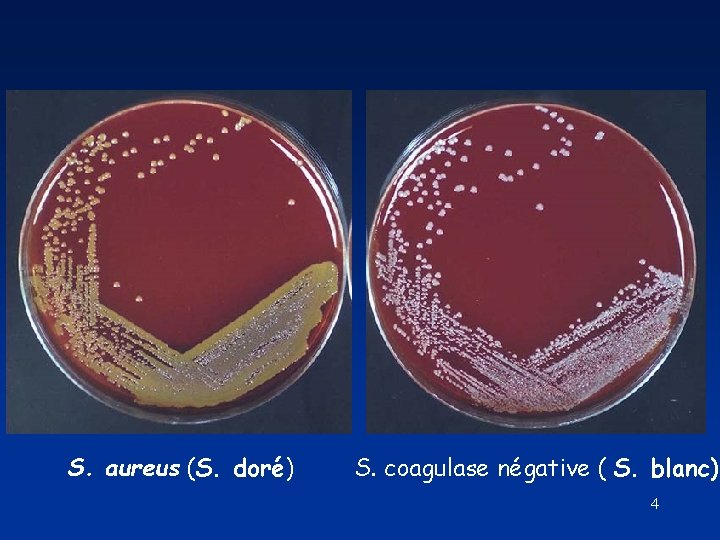
S. aureus (S. doré) S. coagulase négative ( S. blanc) 4 S. aureus (S. doré) S. coagulase négative ( S. blanc) 4

Infections staphylocoque 1 Un peu dhistoire 1880 dcouverte

- Slides: 23
Infections à staphylocoque 1
Un peu d’histoire… • 1880: découverte de germes dans un pus par Pasteur • 1883: nom de « Staphylocoque » donné par Ogston (grains: kokkos; grappe de raisin: staphylê ) • 1884: cultures par Rosenbach, séparation en deux groupes: colonies blanches et dorées 2
Infections à staphylocoques Agent causal Staphylococcus : cocci à Gram positif en amas (grappe de raisin ou tétrades) - très résistant dans le milieu extérieur - on distingue : coagulase POSITIVE : S. aureus (S. doré) coagulase NEGATIVE : S. blanc : S. epidermidis, S. saprophyticus, S. hominis, S. haemolyticus … 3
S. aureus (S. doré) S. coagulase négative ( S. blanc) 4
Mise en évidence de la coagulase libre 0, 5 ml de culture bactérienne en bouillon cœur cervelle de 18 h + 0, 5 ml de plasma citraté de lapin 3 à 4 heures à 35°C CAILLOT ? 5
Réservoir - environnement : air, eau, sol, aliments, mobilier, matériels - vit à l ’état commensal sur la peau et les muqueuses des hommes et des animaux réservoir principal du staphylocoque : homme lui-même : - homme malade, porteur de lésions - homme sain qui héberge la bactérie au niveau des fosses nasales, de l ’intestin, de la peau (mains, creux axillaire, périnée) et de la gorge. Rq : 80 % de porteurs sains dans le personnel soignant !! 6
Niches écologiques S. aureus S. epidermidis S. capitis S. epidermidis S. haemolyticus S. hominis S. aureus S. auricularis S. epidermidis S. hominis S. epidermidis S. saprophyticus 7
Habitat et épidémiologie Habitat préférentiel de SAU: muqueuse nasale En dehors de tout contact hospitalier 20% - 60% - 20% Porteurs permanents Non Porteurs transitoires 8
Transmission - directe : inter-humaine à partir des lésions ouvertes, par contact, par dissémination manu portée. - indirecte : objets contaminés (en milieu hospitalier : vêtements, literies, objets usuels, matériel médical) aliments 9
Pathogénie - porte d ’entrée : cutanée (le plus souvent) : plaie (même minime), excoriation, point de pénétration d ’un cathéter, brûlures, dermatose… - facteurs de virulence et de pathogénicité de S. aureus : > toxines (hémolysines, leucocidine, entérotoxine, toxine du syndrome du choc toxique TSST-1, toxine épidermolytique) > enzymes (coagulase rôle dans les thrombophlébites; fibrinolysine embols septiques métastases à l ’origine de foyers II) - aptitude à adhérer aux épithéliums et structures inertes (corps étranger, prothèse), et production d ’un 10 biofilm
Clinique des infections à S. aureus 1. Infections cutanées, sous-cutanées et muqueuses - épidermiques : impétigo, dermatose bulleuse - follicule pilo-sébacé : folliculite (abcès de la gaine du poil) qui peut aboutir à la nécrose de tout l ’appareil pilo-sébacé et donner un furoncle ou de l ’anthrax (conglomérats de furoncles) évoluant vers un abcès, une lymphangite ou une bactériémie. - tissu sous-cutané : abcès, panaris, cellulite. . 2. Infections de la sphère ORL - sinusite, otite, angine. . . 11
3. Autres localisations - vasculaire : lymphangite, phlébite - pleuro-pulmonaire : abcès bulleux - ostéoarticulaire (traumatologie, chirurgie orthopédique) - cardiaque : endocardites : > sur valves natives : dues à une infection sur cathéter veineux, sur fistule artérioveineuse, chez les toxicomanes (IV) > sur valves prothétiques (S. epidermidis) - cérébro-méningées : abcès du cerveau, méningite - génito- urinaire : pyélonéphrite chez le diabétique 12
4. Septicémies à S. aureus passage du staphylocoque dans le sang à partir d ’un foyer primaire compliqué de thrombophlébite. - graves, risques de métastases septiques 5. Toxi-infections alimentaires - dues à l ’ingestion d ’entérotoxine préformée dans l ’aliment - troubles d ’apparition précoce (moins de 3 h) : vomissements, diarrhées, déshydratation, absence de fièvre - évolution bénigne sauf chez le nourrisson et le sujet âgé (déshydratation) 13
6. Entérocolite staphylococcique post-antibiotique - exceptionnelle - due à la prolifération de staphylocoque antibiorésistant et producteur d ’entérotoxine (ces bactéries doivent être recherchées dans les selles). 7. Syndrome de choc toxique staphylococcique - décrit en 1978 aux Etats- Unis, chez les femmes en période menstruelle utilisant des tampons périodiques - due à la toxine TSST-1 du S. aureus - fièvre, hypotension, érythrodermie suivie d ’une desquamation scarlatiniforme au niveau de la paume des mains et de la plante des pieds et atteinte pluriviscérale. 14
Diagnostic 1. Direct +++ - les prélèvements doivent être pratiqué AVANT toute antibiothérapie et dans des conditions d’asepsie rigoureuse. - hémocultures, LCR, urines, pus, biopsie, aspiration bronchique, écouvillonnage. - la présence de staphylocoque aureus ( et à plus forte raison de staphylocoque coagulase négative) n ’est pas obligatoirement synonyme d ’infection. examen direct microscopique après coloration de Gram : cocci Gram positif en amas (tétrades, grappe de raisin) = indication diagnostic importante mais la certitude n ’est 15 obtenue qu’après la culture.
culture facile (milieux standards, milieu sélectif), colonie de couleur jaune. identification : tests positifs pour S. aureus - COAGULASE - agglutination au latex - DNase ces tests sont négatifs pour les staphylocoques blancs antibiogramme (étude de la sensibilité de la bactérie aux antibiotiques) est indispensable. 2. Indirect : sérologie = dosage des anticorps antistaphylolysines et antiacide téichoïque - peut être intéressant dans certaines situations mais ne remplace pas la culture. 16
Traitement - antibiogramme indispensable, car la sensibilité des souches aux antibiotiques est en constante évolution. ( méthode en milieu liquide, méthode en milieu gélosé avec disque ou bandelette imprégnée d ’antibiotique) - > 95 % des souches sont résistantes à la pénicilline G - staphylocoque d ’origine communautaire : 90 % sont sensible à la méticilline (ou oxacilline) = méti S - staphylocoque d ’origine hospitalière : 20 à 60 % sont résistant à la méticilline (ou oxacilline) = méti R cette résistance peut s ’accompagner d ’une résistance à toutes les céphalosporines et aux fluoroquinolones, aux macrolides et aux aminosides 17
- la vancomycine, la téicoplanine , la rifampicine, l ’acide fusidique et la fosfomycine restent actifs (le plus souvent). Indications du traitement staphylococcies superficielles : pas obligatoirement d ’antibiotique (panaris et abcès doivent être incisés) staphylococcies profondes : choix de l ’antibiotique fonction de : - la sensibilité du germe - des propriétés de diffusion de l ’antibiotique au niveau du siège de l ’infection - de la gravité de l ’infection 18
Prophylaxie des staphylococcies - prévention des toxi-infections alimentaires collectives : stricte application des règles d ’hygiène professionnelle (hygiène des mains, des tenues, des locaux …) - recherche et éradication des gîtes staphylococciques chez les porteurs - traitement des lésions pouvant représenter une porte d ’entrée pour des infections plus graves - antibioprophylaxie per-opératoire (en chirurgie orthopédique et cardio-vasculaire) : - recherche et éradication de tout foyer staphylococcique les jours précédent l ’intervention - antibiotique antistaphylococcique pdt 24 h 19
- respecter les règles d ’hygiène hospitalière : lavages des mains, désinfection soigneuse lors de tout geste invasif (pose de cathéter …) 20
Infections à staphylocoques à coagulase négative (staphylocoques blancs) = bactéries opportunistes responsables d ’infections nosocomiales ou iatrogènes - dans certains secteurs chirurgicaux : chirurgie cardiovasculaire, neurologique, orthopédique - touchent les sujets au terrain particulièrement fragilisé : cancérologie, néonatalogie, SIDA … - sont souvent la conséquence des techniques de perfusion ou de la mise en place de matériel étranger 21
Clinique - infections développées sur cathéter (phlébite, cellulite, lymphangite), cathéter de dialyse (bactériémie, péritonite) - endocardite post-opératoire (matériel) - infections neuro-méningées (néonatale, post-opératoire) - ostéo-arthrites post-opératoires essentiellement après prothèse totale de hanche, de genou - bactériémies chez les immunodéprimés (hémopathie, transplanté) après les infections précédentes - infections oculaires post-opératoires - infections urinaires basses chez la jeune femme 22
Diagnostic Ce sont des hôtes habituels de la peau et des muqueuses. Pour affirmer ces infections, il est nécessaire d ’avoir des critères rigoureux : présence des germes - dans 2 hémocultures faites à 24 h d ’intervalle - au niveau de la porte d ’entrée, des cathéters, du matériel retiré lors d ’une intervention Traitement Comme pour les staphylocoques dorés, mais ils sont souvent plus résistants. 23